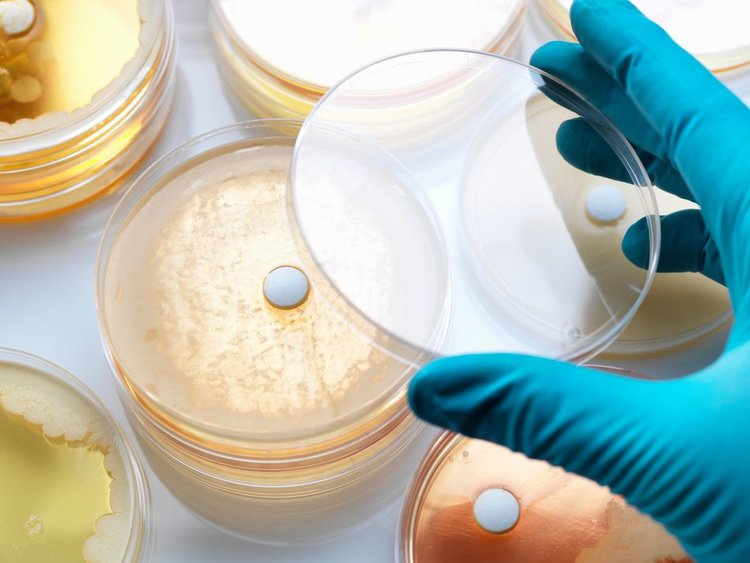

Khi nhắc tới công nghệ sinh học, người ta thường nghĩ đến nghiên cứu y sinh, nhưng bên cạnh đó, nhiều ngành công nghiệp khác cũng đang tận dụng các phương pháp công nghệ sinh học để nghiên cứu, nhân bản và thay đổi gen. Công nghệ sinh học nông nghiệp đã sản xuất vô số sản phẩm mới có tiềm năng thay đổi cuộc sống của chúng ta.
1. Vắc-xin
Vắc-xin uống đã được sử dụng như một giải pháp khả thi cho sự lây lan của bệnh tật ở các nước kém phát triển, nơi mà chi phí việc tiêm phòng rất hạn chế. Nhờ công nghệ sinh học nông nghiệp, cây trồng biến đổi gen (thường là trái cây hoặc rau quả) đã được thiết kế để mang protein kháng nguyên từ mầm bệnh truyền nhiễm, cơ thể người sẽ kích hoạt phản ứng miễn dịch khi ăn.

Một ví dụ điển hình là vắc-xin dành riêng cho bệnh nhân để điều trị ung thư. Một loại vắc-xin chống ung thư hạch đã được thực hiện bằng cách sử dụng cây thuốc lá mang RNA (Axit ribonucleic) từ các tế bào B ác tính nhân bản. Protein thu được sau đó được sử dụng để tiêm phòng cho các bệnh nhân nhằm tăng cường hệ thống miễn dịch chống lại ung thư. Thông qua nhiều nghiên cứu sơ bộ, vắc-xin được chế tạo để điều trị ung thư đã cho thấy nhiều triển vọng.
2. Kháng sinh
Thực vật được sử dụng để sản xuất kháng sinh cho cả người và động vật. Một số lợi thế của việc sử dụng thực vật để sản xuất kháng sinh cho con người là giảm chi phí do thực vật có thể cung cấp lượng sản phẩm lớn, dễ thanh lọc và giảm nguy cơ truyền nhiễm so với sử dụng tế bào và nuôi cấy trên động vật.
3. Hoa và cây trồng
Bên cạnh việc phòng chống dịch bệnh và cải thiện chất lượng sản phẩm, công nghệ sinh học còn tác dụng trong mặt thẩm mỹ. Cụ thể, các kĩ thuật nhận dạng và chuyển đổi gen đã được áp dụng để cải thiện màu sắc, mùi hương, kích thước và 1 số tính chất khác của hoa.
Ngoài ra, công nghệ sinh học còn giúp cây trồng tăng cường khả năng chống lạnh của một giống cây nhiệt đới để có thể trồng các loại cây này ở phía bắc.

4. Nhiên liệu sinh học (biofuels)
Nông nghiệp đóng vai trò lớn trong ngành công nghiệp nhiên liệu sinh học, cung cấp nguyên liệu cho quá trình lên men và tinh chế nhiên liệu sinh học (bao gồm bio-oil, bio-diesel, và bio-ethanol).

Kỹ thuật di truyền và kỹ thuật tối ưu hóa enzyme đang được sử dụng để phát triển các nguyên liệu chất lượng tốt hơn nhằm tăng cường chất lượng và sản lượng của các sản phẩm nhiên liệu thu được. Cây trồng năng suất cao, có khả năng cung cấp nhiều năng lượng giúp giảm thiểu chi phí thu hoạch và vận chuyển, dẫn đến các sản phẩm nhiên liệu sinh học có giá trị cao hơn.
5. Nhân giống cây trồng và vật nuôi
Việc cải thiện các đặc điểm của thực vật và động vật thông qua các phương pháp truyền thống như thụ phấn chéo, ghép và nhân giống chéo thường gây tốn thời gian. Công nghệ sinh học nông nghiệp hiện nay cho phép các thay đổi cụ thể được thực hiện nhanh chóng ở cấp độ phân tử hoặc xóa gen hoặc ghép gen ngoại lai.

Hiện nay, các nhà khoa học có thể sử dụng các cơ chế kiểm soát biểu hiện gen như các yếu tố thúc đẩy gen cụ thể và các yếu tố phiên mã trong nhân giống vật nuôi và cây trồng.
6. Cây trồng kháng sâu bệnh
Vi khuẩn Bacillus thuringiensis (Bt) đã được phát hiện sản sinh ra một loại protein độc hại đối với côn trùng, đặc biệt là sâu đục thân ngô châu Âu, và được sử dụng để phủ bụi lên cây trồng.
Để giảm bớt việc phủ vi khuẩn Bt lên cây trồng, các nhà khoa học đã phát triển ngô biến đổi gen biểu hiện protein Bt, tiếp theo là khoai tây Bt và bông Bt. Protein Bt không độc hại đối với con người và cây trồng biến đổi gen giúp nông dân giảm thiểu chi phí phủ bụi.

Năm 1999, đã có nhiều tranh cãi về ngô Bt vì một nghiên cứu cho thấy phấn hoa đã giết chết ấu trùng bướm sau khi ấu trùng ăn vào. Các nghiên cứu sau đó đã chứng minh nguy cơ tử vong có thể xảy ra đối với ấu trùng rất thấp.
7. Cây trồng kháng thuốc trừ sâu
Với cây trồng kháng thuốc trừ sâu, nông dân có thể tiêu diệt cỏ dại xung quanh mà không cần lo lắng sẽ làm ảnh hưởng đến cây.

Ví dụ nổi tiếng nhất về loại cây trồng khác thuốc trừ sâu này là công nghệ Roundup-Ready được phát triển bởi Monsanto. Được giới thiệu lần đầu tiên vào năm 1998 dưới dạng đậu nành GM, các cây Roundup-Ready không bị ảnh hưởng bởi thuốc diệt cỏ glyphosate, người dân có thể áp dụng thuốc diệt cỏ với số lượng lớn để loại bỏ bất kỳ loại cây nào khác trên cánh đồng. Lợi ích của việc này là tiết kiệm thời gian và chi phí liên quan đến việc làm đất thông thường để diệt cỏ dại hoặc sử dụng nhiều loại thuốc diệt cỏ khác nhau để loại bỏ các loài cỏ dại cụ thể một cách chọn lọc.
8. Bổ sung chất dinh dưỡng
Các nhà khoa học đang tạo ra các loại thực phẩm biến đổi gen có chứa các chất dinh dưỡng giúp chống lại bệnh tật hoặc suy dinh dưỡng, nhằm cải thiện sức khỏe của con người, đặc biệt là ở các nước kém phát triển.

Một ví dụ về điều này là Golden Rice (gạo vàng), có chứa beta-carotene, tiền chất để sản xuất Vitamin A trong cơ thể chúng ta. Những người ăn gạo này có thể sản sinh ra nhiều Vitamin A trong cơ thể, một chất dinh dưỡng thiết yếu còn thiếu trong chế độ ăn uống của người nghèo ở các nước châu Á. Ba loại gen lấy từ hoa thủy tiên và vi khuẩn có khả năng xúc tác bốn phản ứng sinh hóa, đã được nhân bản vào cây lúa để làm hạt gạo trở nên ‘vàng’. Tên này xuất phát từ màu của hạt gạo chuyển gen do chứa beta-carotene, chất tạo ra màu da cam của cà rốt.
9. Kháng stress phi sinh học
Đất trồng trọt chiếm dưới 20% diện tích trái đất, vì thế việc giúp cây trồng có thể chịu đựng được các điều kiện khắc nghiệt như nhiễm mặn, lạnh và hạn hán là rất cần thiết. Việc phát hiện ra các gen trong cây trồng chịu trách nhiệm hấp thu natri (Na) đã dẫn đến sự phát triển của các loại thực vật có khả năng sinh trưởng trong môi trường có hàm lượng muối cao. Điều chỉnh tăng hoặc giảm phiên mã nói chung là phương pháp được sử dụng để thay đổi khả năng chịu hạn ở cây trồng. California và Colorado đang trong quá trình thử nghiệm loại ngô và cây cải dầu có thể phát triển mạnh trong điều kiện khô hạn, và dự đoán rằng chúng sẽ tiếp cận thị trường trong 4-5 năm tới.

10. Vật liệu siêu bền trong công nghiệp
Tơ nhện là loại sợi mạnh nhất mà con người từng biết đến, mạnh hơn Kevlar (dùng để chế tạo áo chống đạn) và có độ bền kéo cao hơn thép. Vào tháng 8 năm 2000, công ty Nexia của Canada đã công bố phát triển dê biến đổi gen sản xuất protein tơ nhện trong sữa của chúng.

Mặc dù điều này giúp giải quyết vấn đề sản xuất protein hàng loạt, chương trình đã bị gác lại khi các nhà khoa học không thể tìm ra cách quay chúng thành sợi như cách những con nhện làm. Vì thế đến năm 2005, những con dê biến đổi gen này đã được rao bán cho bất cứ ai muốn lấy chúng.
Mặc dù có vẻ như ý tưởng tơ nhện đã bị gác lại, nhưng hiện tại, đây là một công nghệ chắc chắn sẽ xuất hiện trở lại trong tương lai, khi người ta tìm ra cách dệt vải từ tơ nhện.
Nguồn doimoisangtao.vn
